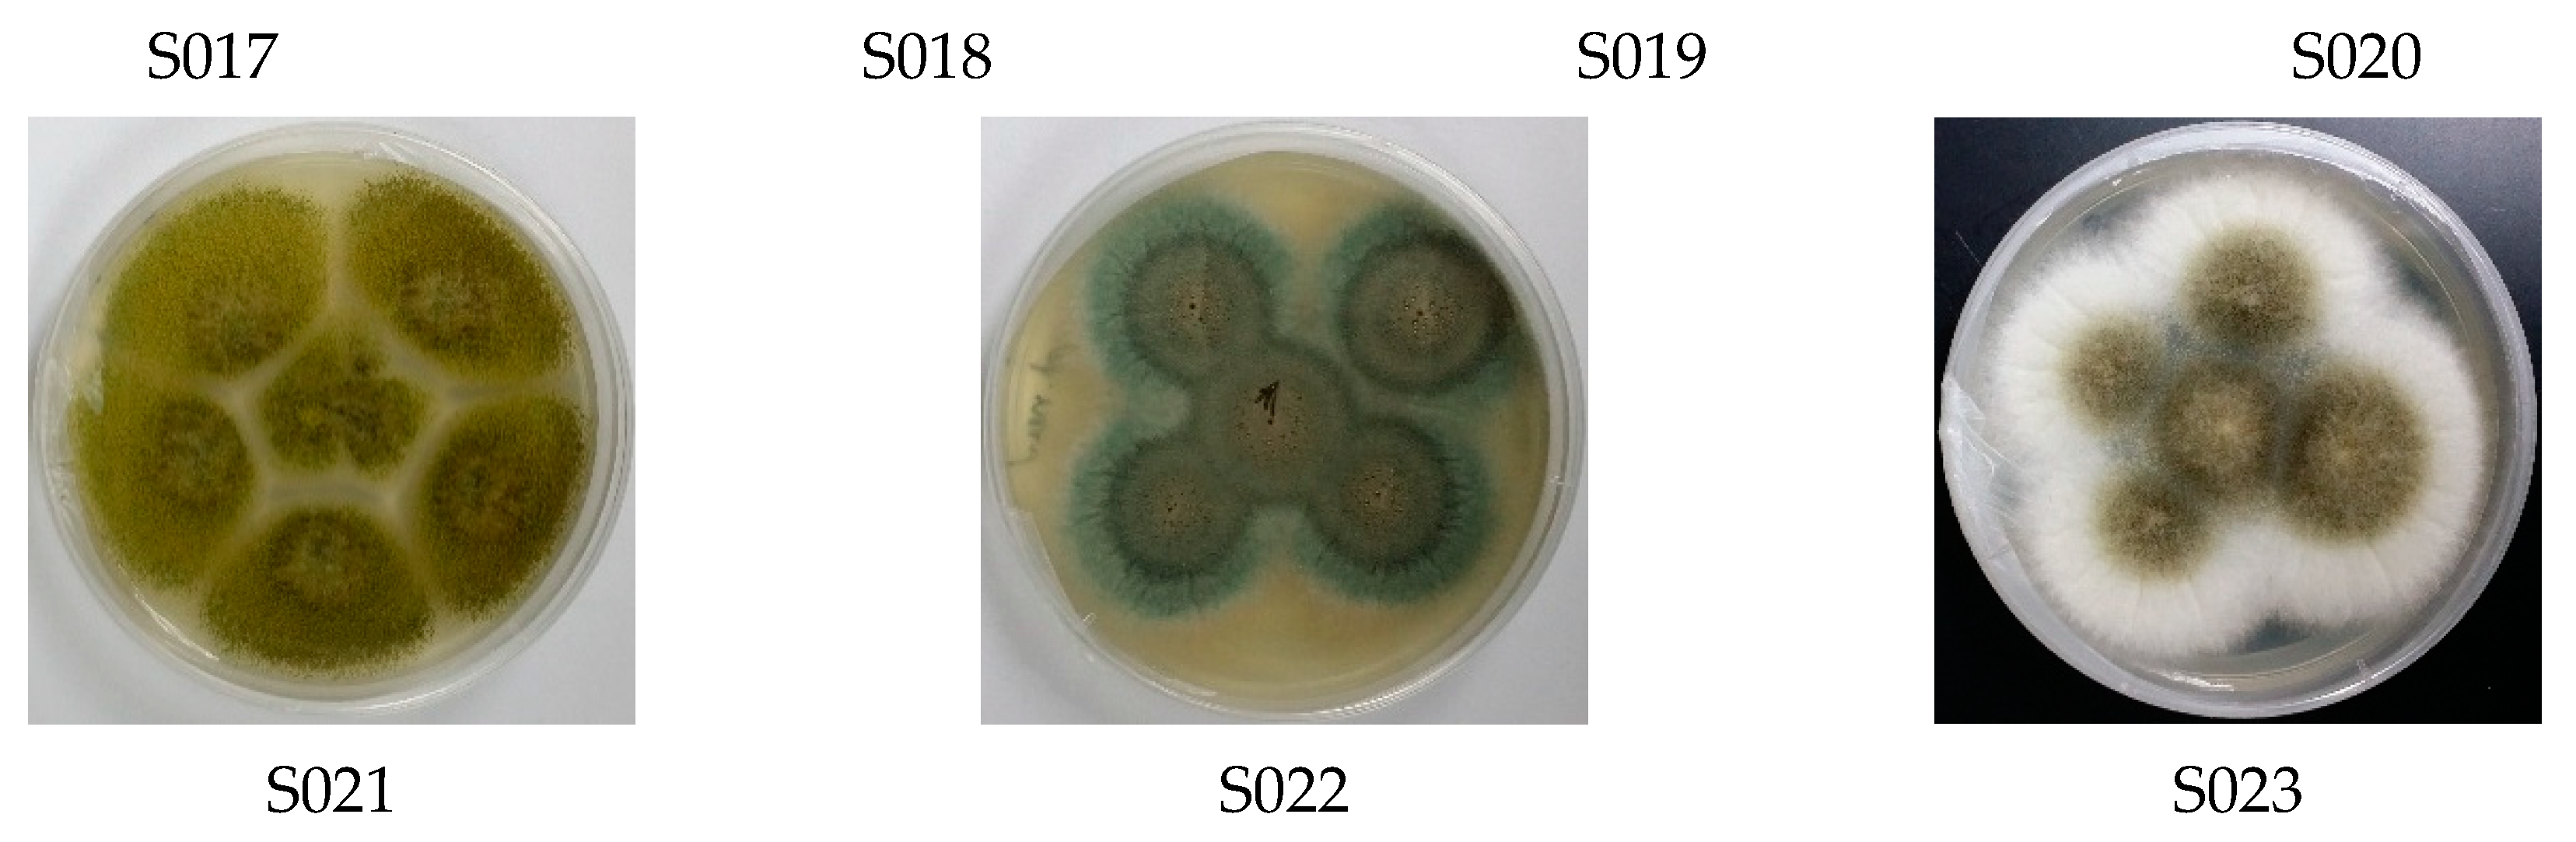
Biomolecules 09 00480 g001b Biomolecules 09 00480 g001b

Large-Scale Production of Bioactive Terrein by Aspergillus terreus Strain S020 Isolated from the Saudi Coast of the Red Sea
Abstract
1. Introduction
2. Experimental Section
2.1. Biological Materials
2.2. Fungi Isolation
2.2.1. Sponge Samples
2.2.2. Sediment Samples
2.3. DNA Genome Extraction from Pure Subcultured Fungal Isolates
2.4. Internal Transcribed Spacer-rDNA (ITS-rDNA) Fragments Amplification, Sequencing, and Phylogenetic Analysis of Fungal Isolates
2.5. Fermentation and Preparation of Extracts of the Fungal Isolate S020
2.6. Isolation and Purification of Terrein
2.7. Biological Activity
2.7.1. Preparation of the Extracts of Isolates S001–S023
2.7.2. Antimicrobial and Cytotoxic Activities of Fungal Extracts of Isolates S001–S023
3. Results and Discussion
3.1. Diversity of Culturable Fungal Strains Derived from the Marine Samples
3.2. Large-Scale Production and Purification of Terrein from A. terreus Strain S020
3.3. Structure Elucidation of the Isolated Terrein
3.4. Biological Activities
3.4.1. Antimicrobial Activities of the Fungal Extracts
3.4.2. Antiproliferative Activities of the Fungal Extracts
3.4.3. Cytotoxic Activity of the Isolated Compound Terrein
4. Conclusions
Supplementary Materials
Author Contributions
Funding
Conflicts of Interest
References
- Malakoff, D. Extinction on the high seas. Science 1997, 277, 486–488. [Google Scholar] [CrossRef]
- Pomponi, S.A. The bioprocess-technological potential of the sea. J. Biotechnol. 1999, 70, 5–13. [Google Scholar] [CrossRef]
- Winston, J.E. The systematists’ perspective. In Biomedical Importance of Marine Organisms; Fautin, D.G., Ed.; Memoirs of the California Academy of Sciences: San Francisco, CA, USA, 1988; Volume 13, pp. 1–6. [Google Scholar]
- Faulkner, D.J. Marine natural products. Nat. Prod. Rep. 2000, 17, 7–55. [Google Scholar] [CrossRef] [PubMed]
- Faulkner, D.J. Marine pharmacology. Antonie Van Leeuwenhoek 2000, 77, 135–145. [Google Scholar] [CrossRef] [PubMed]
- Bhadury, P.; Wright, P. Exploitation of marine algae: Biogenic compounds for potential antifouling applications. Planta 2004, 219, 561–578. [Google Scholar] [CrossRef]
- Donia, M.; Hamann, M.T. Marine natural products and their potential applications as anti-infective agents. Lancet Infect. Dis. 2003, 3, 338–348. [Google Scholar] [CrossRef]
- Mayer, A.M.; Hamann, M.T. Marine pharmacology in 2000: Marine compounds with antibacterial, anticoagulant, antifungal, anti-inflammatory, antimalarial, antiplatelet, antituberculosis, and antiviral activities; affecting the cardiovascular, immune, and nervous systems and other miscellaneous mechanisms of action. Mar. Biotechnol. 2004, 6, 37–52. [Google Scholar]
- Mehta, A.S.; Gu, B.; Conyers, B.; Ouzounov, S.; Wang, L.; Moriarty, R.M.; Dwek, R.A.; Block, T.M. α-Galactosylceramide and Novel Synthetic Glycolipids Directly Induce the Innate Host Defense Pathway and Have Direct Activity against Hepatitis B and C Viruses. Antimicrob. Agents Chemother. 2004, 48, 2085–2090. [Google Scholar] [CrossRef]
- Rowley, D.C.; Hansen, M.S.; Rhodes, D.; Sotriffer, C.A.; Ni, H.; McCammon, J.; Bushman, F.D.; Fenical, W. Thalassiolins A–C: New marine-derived inhibitors of HIV cDNA integrase. Bioorganic Med. Chem. 2002, 10, 3619–3625. [Google Scholar] [CrossRef]
- Lopes, R.; Schwartsmann, G.; Da Rocha, A.B.; Mattei, J. Marine-derived anticancer agents in clinical trials. Expert Opin. Investig. Drugs 2003, 12, 1367–1383. [Google Scholar] [CrossRef]
- Mayer, A.M.; Rodriguez, A.D.; Berlinck, R.G.; Fusetani, N. Marine pharmacology in 2007–8: Marine compounds with antibacterial, anticoagulant, antifungal, anti-inflammatory, antimalarial, antiprotozoal, antituberculosis, and antiviral activities; affecting the immune and nervous system, and other miscellaneous mechanisms of action. Comp. Biochem. Physiol. Part C: Toxicol. Pharmacol. 2011, 153, 191–222. [Google Scholar]
- Kelecom, A. Secondary metabolites from marine microorganisms. Anais da Academia Brasileira de Ciências 2002, 74, 151–170. [Google Scholar] [CrossRef] [PubMed]
- Bugni, T.S.; Ireland, C.M. Marine-Derived Fungi: A Chemically and Biologically Diverse Group of Microorganisms. Nat. Prod. Rep. 2004, 35, 143–163. [Google Scholar] [CrossRef]
- Bhadury, P.; Mohammad, B.T.; Wright, P.C. The current status of natural products from marine fungi and their potential as anti-infective agents. J. Ind. Microbiol. Biotechnol. 2006, 33, 325–337. [Google Scholar] [CrossRef] [PubMed]
- Abdel-Lateff, A.; Klemke, C.; König, G.M.; Wright, A.D. Two New Xanthone Derivatives from the Algicolous Marine Fungus Wardomyces anomalus. J. Nat. Prod. 2003, 66, 706–708. [Google Scholar] [CrossRef]
- Klemke, C.; Kehraus, S.; Wright, A.D.; König, G.M. New Secondary Metabolites from the Marine Endophytic Fungus Apiospora montagnei. J. Nat. Prod. 2004, 67, 1058–1063. [Google Scholar] [CrossRef]
- Vongvilai, P.; Isaka, M.; Kittakoop, P.; Srikitikulchai, P.; Kongsaeree, P.; Thebtaranonth, Y. Ketene Acetal and Spiroacetal Constituents of the Marine Fungus Aigialus parvus BCC 5311. J. Nat. Prod. 2004, 67, 457–460. [Google Scholar] [CrossRef]
- Youssef, D.T.A.; Alahdal, A.M. Cytotoxic and Antimicrobial Compounds from the Marine-Derived Fungus, Penicillium Species. Molecules 2018, 23, 394. [Google Scholar] [CrossRef]
- Shaala, L.A.; Youssef, D.T.A. Identification and Bioactivity of Compounds from the Fungus Penicillium sp. CYE-87 Isolated from a Marine Tunicate. Mar. Drugs 2015, 13, 1698–1709. [Google Scholar] [CrossRef]
- Yurchenko, A.N.; Smetanina, O.F.; Ivanets, E.V.; Kalinovsky, A.I.; Khudyakova, Y.V.; Kirichuk, N.N.; Popov, R.S.; Bokemeyer, C.; von Amsberg, G.; Chingizova, E.A. Pretrichodermamides D–F from a marine algicolous fungus Penicillium sp. KMM 4672. Mar. Drugs 2016, 14, 122. [Google Scholar] [CrossRef]
- Park, H.B.; Kim, Y.-J.; Park, J.-S.; Yang, H.O.; Lee, K.R.; Kwon, H.C. Glionitrin B, a Cancer Invasion Inhibitory Diketopiperazine Produced by Microbial Coculture. J. Nat. Prod. 2011, 74, 2309–2312. [Google Scholar] [CrossRef] [PubMed]
- Meng, L.-H.; Zhang, P.; Li, X.-M.; Wang, B.-G. Penicibrocazines A–E, Five New Sulfide Diketopiperazines from the Marine-Derived Endophytic Fungus Penicillium brocae. Mar. Drugs 2015, 13, 276–287. [Google Scholar] [CrossRef] [PubMed]
- Li, Y.; Li, X.; Kim, S.-K.; Kang, J.S.; Choi, H.D.; Rho, J.R.; Son, B.W. Golmaenone, a New Diketopiperazine Alkaloid from the Marine-Derived Fungus Aspergillus sp. Chem. Pharm. Bull. 2004, 35, 375–376. [Google Scholar] [CrossRef] [PubMed]
- Murshid, S.S.; Badr, J.M.; Youssef, D.T. Penicillosides A and B: new cerebrosides from the marine-derived fungus Penicillium species. Rev. Bras. de Farm. 2016, 26, 29–33. [Google Scholar] [CrossRef]
- Asiri, I.A.; Badr, J.M.; Youssef, D.T. Penicillivinacine, antimigratory diketopiperazine alkaloid from the marine-derived fungus Penicillium vinaceum. Phytochem. Lett. 2015, 13, 53–58. [Google Scholar] [CrossRef]
- Mourshid, S.S.; Badr, J.M.; Risinger, A.L.; Mooberry, S.L.; Youssef, D.T. Penicilloitins A and B, new antimicrobial fatty acid esters from a marine endophytic Penicillium species. Zeitschrift für Naturforschung C 2016, 71, 387–392. [Google Scholar] [CrossRef] [PubMed]
- Raistrick, H.; Smith, G. Studies in the biochemistry of micro-organisms: The metabolic products of Aspergillus terreus Thom. A new mould metabolic product-terrein. Biochem.J. 1935, 29, 606–611. [Google Scholar]
- Yin, Y.; Ding, Y.; Feng, G.; Li, J.; Xiao, L.; Karuppiah, V.; Sun, W.; Zhang, F.; Li, Z. Modification of artificial sea water for the mass production of (+)-terrein by Aspergillus terreus strain PF 26 derived from marine sponge Phakellia fusca. Lett. Appl. Microbiol. 2015, 61, 580–587. [Google Scholar] [CrossRef]
- Ghisalberti, E.L.; Narbey, M.J.; Rowland, C.Y. Metabolites of Aspergillus terreus antagonistic towards the take-all fungus. J. Nat. Prod. 1990, 53, 520–522. [Google Scholar] [CrossRef]
- Arakawa, M.; Someno, T.; Kawada, M.; Ikeda, D. A New Terrein Glucoside, a Novel Inhibitor of Angiogenin Secretion in Tumor Angiogenesis. J. Antibiot. 2008, 61, 442–448. [Google Scholar] [CrossRef]
- Park, S.-H.; Kim, D.-S.; Kim, W.-G.; Ryoo, I.-J.; Lee, D.-H.; Huh, C.-H.; Youn, S.W.; Yoo, I.-D.; Park, K.-C. Terrein: A new melanogenesis inhibitor and its mechanism. Cell. Mol. Life Sci. 2004, 61, 2878–2885. [Google Scholar] [CrossRef]
- Kim, D.-S.; Cho, H.-J.; Lee, H.-K.; Lee, W.-H.; Park, E.-S.; Youn, S.-W.; Park, K.-C. Terrein, a fungal metabolite, inhibits the epidermal proliferation of skin equivalents. J. Dermatol. Sci. 2007, 46, 65–68. [Google Scholar] [CrossRef]
- Lee, J.-C.; Yu, M.-K.; Lee, R.; Lee, Y.-H.; Jeon, J.-G.; Lee, M.-H.; Jhee, E.-C.; Yoo, I.-D.; Yi, H.-K. Terrein Reduces Pulpal Inflammation in Human Dental Pulp Cells. J. Endod. 2008, 34, 433–437. [Google Scholar] [CrossRef]
- Lee, Y.-H.; Lee, N.-H.; Bhattarai, G.; Oh, Y.-T.; Yu, M.-K.; Yoo, I.-D.; Jhee, E.-C.; Yi, H.-K. Enhancement of osteoblast biocompatibility on titanium surface with Terrein treatment. Cell Biochem. Funct. 2010, 28, 678–685. [Google Scholar] [CrossRef]
- Auerbach, J.; Weinreb, S.M. Synthesis of terrein, a metabolite of Aspergillus terreus. J. Chem. Soc. Chem. Commun. 1974, 8, 298–299. [Google Scholar] [CrossRef]
- Barton, D.H.R.; Hulshof, L.A. Photochemical transformations. Part 35. A simple synthesis of racemic terrein. J. Chem. Soc. Perkin Trans. 1 1977, 9, 1103–1106. [Google Scholar] [CrossRef]
- Klunder, A.; Bos, W.; Zwanenburg, B. An efficient stereospecific total synthesis of (±) terrein. Tetrahedron Lett. 1981, 22, 4557–4560. [Google Scholar] [CrossRef]
- Lee, S.; Kim, W.-G.; Kim, E.; Ryoo, I.-J.; Lee, H.K.; Kim, J.N.; Jung, S.-H.; Yoo, I.-D. Synthesis and melanin biosynthesis inhibitory activity of (±)-terrein produced by Penicillium sp. 20135. Bioorg. Med. Chem. Lett. 2005, 15, 471–473. [Google Scholar] [CrossRef]
- Altenbach, H.J.; Holzapfel, W. Synthesis of (+)-Terrein from L-Tartaric Acid. Angew. Chem. Int. Ed. Engl. 1990, 29, 67–68. [Google Scholar] [CrossRef]
- Kolb, H.C.; Martin, H.; Hoffmann, R. A total synthesis of racemic and optically active terrein (trans-4, 5-dihydroxy-3-[(E)-1-propenyl]-2-cyclopenten-1-one). Tetrahedron 1990, 1, 237–250. [Google Scholar] [CrossRef]
- Kim, W.-G.; Ryoo, I.-J.; Park, S.-H.; Kim, D.-S.; Lee, S.; Park, K.-C.; Yoo, I.-D. Terrein, a melanin biosynthesis inhibitor, from Penicillium sp. 20135. J. Microbiol. Biotechnol. 2005, 15, 891–894. [Google Scholar]
- Phattanawasin, P.; Pojchanakom, K.; Sotanaphun, U.; Piyapolrungroj, N.; Zungsontiporn, S. Weed growth inhibitors from Aspergillus fischeri TISTR 3272. Nat. Prod. Res. 2007, 21, 1286–1291. [Google Scholar] [CrossRef] [PubMed]
- Demasi, M.; Felicio, A.L.; Pacheco, A.O.; Leite, H.G.; Lima, C.; Andrade, L.H. Studies on terrein as a new class of proteasome inhibitors. J. Braz. Chem. Soc. 2010, 21, 299–305. [Google Scholar] [CrossRef]
- Wang, Y.; Zheng, J.; Liu, P.; Wang, W.; Zhu, W. Three New Compounds from Aspergillus terreus PT06-2 Grown in a High Salt Medium. Mar. Drugs 2011, 9, 1368–1378. [Google Scholar] [CrossRef] [PubMed]
- Xu, B.; Yin, Y.; Zhang, F.; Li, Z.; Wang, L. Operating conditions optimization for (+)-terrein production in a stirred bioreactor by Aspergillus terreus strain PF-26 from marine sponge Phakellia fusca. Bioprocess Biosyst. Eng. 2012, 35, 1651–1655. [Google Scholar] [CrossRef] [PubMed]
- Yin, Y.; Gao, Q.; Zhang, F.; Li, Z. Medium optimization for the high yield production of single (+)-terrein by Aspergillus terreus strain PF26 derived from marine sponge Phakellia fusca. Process Biochem. 2012, 47, 887–891. [Google Scholar] [CrossRef]
- Xiao, L.; Yin, Y.; Sun, W.; Zhang, F.; Li, Z. Enhanced production of (+)-terrein by Aspergillus terreus strain PF26 with epigenetic modifier suberoylanilide hydroxamic acid. Process Biochem. 2013, 48, 1635–1639. [Google Scholar] [CrossRef]
- Yin, Y.; Xu, B.; Li, Z.; Zhang, B. Enhanced production of (+)-terrein in fed-batch cultivation of Aspergillus terreus strain PF26 with sodium citrate. World J. Microbiol. Biotechnol. 2013, 29, 441–446. [Google Scholar] [CrossRef]
- Elhady, S.S.; El-Halawany, A.M.; Alahdal, A.M.; Hassanean, H.A.; Ahmed, S.A. A New Bioactive Metabolite Isolated from the Red Sea Marine Sponge Hyrtios erectus. Molecules 2016, 21, 82. [Google Scholar] [CrossRef]
- Elhady, S.S.; Al-Abd, A.M.; El-Halawany, A.M.; Alahdal, A.M.; Hassanean, H.A.; Ahmed, S.A. Antiproliferative Scalarane-Based Metabolites from the Red Sea Sponge Hyrtios erectus. Mar. Drugs 2016, 14, 130. [Google Scholar] [CrossRef]
- Alahdal, A.M.; Shaala, L.A.; Noor, A.O.; Elfaky, M.A.; Elhady, S.S.; Almohammadi, A.; Bagalagel, A.; Lashkar, M.O.; Almasri, D.M.; Youssef, D. Evaluation of the antiproliferative and cytotoxic activities of marine invertebrates-derived fungi. Pak. J. Pharm. Sci. 2017, 30, 1001–1006. [Google Scholar] [PubMed]
- Bagalagel, A.A.; Bogari, H.A.; Ahmed, S.A.; Diri, R.M.; Elhady, S.S. New Bromoindole Alkaloid Isolated from the Marine Sponge Hyrtios erectus. Heterocycles 2018, 96, 749–756. [Google Scholar]
- Alahdal, A.M.; Asfour, H.Z.; Ahmed, S.A.; Noor, A.O.; Al-Abd, A.M.; Elfaky, M.A.; Elhady, S.S. Anti-Helicobacter, Antitubercular and Cytotoxic Activities of Scalaranes from the Red Sea Sponge Hyrtios erectus. Molecules 2018, 23, 978. [Google Scholar] [CrossRef] [PubMed]
- Li, Q.; Wang, G. Diversity of fungal isolates from three Hawaiian marine sponges. Microbiol. Res. 2009, 164, 233–241. [Google Scholar] [CrossRef] [PubMed]
- Wei, J. Fungal Identification Manual; Shanghai Science and Technology Press: Shanghai, China, 1979; p. 496. [Google Scholar]
- White, T.; Bruns, T.; Lee, S.; Taylor, J. Amplification and direct sequencing of fungal ribosomal RNA genes for phylogenetics. PCR Protocols 1990, 18, 315–322. [Google Scholar]
- Thompson, J.D.; Gibson, T.J.; Plewniak, F.; Jeanmougin, F.; Higgins, D.G. The CLUSTAL_X windows interface: Flexible strategies for multiple sequence alignment aided by quality analysis tools. Nucleic Acids Res. 1997, 25, 4876–4882. [Google Scholar] [CrossRef] [PubMed]
- Hall, T.A. BioEdit: A user-friendly biological sequence alignment editor and analysis program for Windows 95/98/NT. Nucleic Acids Symp. Ser. 1999, 41, 95–98. [Google Scholar]
- Tamura, K.; Peterson, D.; Peterson, N.; Stecher, G.; Nei, M.; Kumar, S. MEGA5: Molecular Evolutionary Genetics Analysis Using Maximum Likelihood, Evolutionary Distance, and Maximum Parsimony Methods. Mol. Boil. Evol. 2011, 28, 2731–2739. [Google Scholar] [CrossRef]
- Schoch, C.L.; Seifert, K.A.; Huhndorf, S.; Robert, V.; Spouge, J.L.; Levesque, C.A.; Chen, W.; Consortium, F.B. Nuclear ribosomal internal transcribed spacer (ITS) region as a universal DNA barcode marker for Fungi. Proc. Natl. Acad. Sci. USA 2012, 109, 6241–6246. [Google Scholar] [CrossRef]
- Baker, P.W.; Kennedy, J.; Dobson, A.D.; Marchesi, J.R. Phylogenetic diversity and antimicrobial activities of fungi associated with Haliclona simulans isolated from Irish coastal waters. Mar. Biotechnol. 2009, 11, 540–547. [Google Scholar] [CrossRef]
- Da Silva, M.; Passarini, M.R.Z.; Bonugli, R.C.; Sette, L.D. Cnidarian-derived filamentous fungi from Brazil: Isolation, characterisation and RBBR decolourisation screening. Environ. Technol. 2008, 29, 1331–1339. [Google Scholar] [CrossRef]
- Höller, U.; Wright, A.D.; Matthee, G.F.; König, G.M.; Draeger, S.; Aust, H.-J.; Schulz, B. Fungi from marine sponges: Diversity, biological activity and secondary metabolites. Mycol. Res. 2000, 104, 1354–1365. [Google Scholar] [CrossRef]
- Inderlied, C.; Salfinger, M. Antimicrobial Agents and Susceptibility Tests: Mycobacteria. Manual of Clinical Microbiology, 6th ed.; ASM Press: Washington, DC, USA, 1995; pp. 1385–1404. [Google Scholar]
- Konings, W.N.; Poolman, B.; Driessen, A.J. Can the excretion of metabolites by bacteria be manipulated? FEMS Microbiol. Lett. 1992, 88, 93–108. [Google Scholar] [CrossRef]
- Skehan, P.; Scudiero, D.; Vistica, D.; Bokesch, H.; Kenney, S.; Storeng, R.; Monks, A.; McMahon, J.; Warren, J.T.; Boyd, M.R. New Colorimetric Cytotoxicity Assay for Anticancer-Drug Screening. J. Natl. Cancer Inst. 1990, 82, 1107–1112. [Google Scholar] [CrossRef]
- Evidente, A.; Kornienko, A.; Lefranc, F.; Cimmino, A.; Dasari, R.; Evidente, M.; Mathieu, V.; Kiss, R. Sesterterpenoids with Anticancer Activity. Curr. Med. Chem. 2015, 22, 3502–3522. [Google Scholar] [CrossRef]
- Gomes, N.G.M.; Lefranc, F.; Kijjoa, A.; Kiss, R. Can Some Marine-Derived Fungal Metabolites Become Actual Anticancer Agents? Mar. Drugs 2015, 13, 3950–3991. [Google Scholar] [CrossRef]
- Jin, L.; Quan, C.; Hou, X.; Fan, S. Potential Pharmacological Resources: Natural Bioactive Compounds from Marine-Derived Fungi. Mar. Drugs 2016, 14, 76. [Google Scholar] [CrossRef]
- Imhoff, J.F. Natural Products from Marine Fungi—Still an Underrepresented Resource. Mar. Drugs 2016, 14, 19. [Google Scholar] [CrossRef]

| Marine. Host | Fungal Strain | Culture Media | Pseudomonas aeruginosa | Bacillus subtilis | Staphylococcus aureus | Candida albicans | |||||
|---|---|---|---|---|---|---|---|---|---|---|---|
| Genus | Strain | Broth | Mycelia | Broth | Mycelia | Broth | Mycelia | Broth | Mycelia | ||
| Stylissa carteri | Penicillium | S001 | CZYB | − | +++ | − | − | ++++ | ++++ | − | − |
| Aspergillus | S002 | CZYB | − | +++ | − | − | ++++ | ++++ | − | − | |
| Sediment | Penicillium | S003 | CZYB | − | ++++ | − | − | ++++ | +++ | − | − |
| Aspergillus | S004 | CZYB | − | ++++ | − | − | − | +++ | − | − | |
| Aspergillus | S005 | CZYB | +++ | ++++ | − | − | ++++ | ++++ | − | − | |
| Aspergillus | S006 | CZYB | − | ++++ | − | − | − | ++++ | − | − | |
| Aspergillus | S007 | CZYB | − | ++++ | − | − | − | ++++ | − | − | |
| Pleosporaceae | S008 | CZYB | − | ++++ | − | − | − | ++++ | − | − | |
| Hyrtios erectus | Aspergillus | S009 | MEB | − | − | − | − | − | +++ | − | − |
| Penicillium | S010 | MEB | − | − | − | − | − | +++ | − | − | |
| Penicillium | S011 | MEB | − | +++ | − | − | − | ++++ | − | − | |
| Sediment | Aspergillus | S012 | MEB | − | ++++ | +++ | − | +++ | ++++ | − | − |
| Sediment | Aspergillus | S013 | MEB | − | ++++ | − | − | − | ++++ | ++++ | − |
| H. erectus | Penicillium | S014 | SDB | − | +++ | − | − | +++ | +++ | − | − |
| S. carteri | Penicillium | S015 | SDB | ++++ | +++ | − | − | ++++ | ++++ | − | − |
| Deep Sea | Aspergillus | S016 | SDB | − | ++++ | +++ | − | − | ++++ | − | − |
| Aspergillus | S017 | SDB | +++ | ++++ | +++ | − | +++ | ++++ | − | − | |
| Aspergillus | S018 | SDB | − | ++++ | − | − | − | ++++ | − | − | |
| Sediment | Aspergillus | S019 | SDB | − | +++ | +++ | − | +++ | ++++ | − | − |
| Aspergillus | S020 | SDB | − | ++++ | − | − | − | ++++ | − | − | |
| Aspergillus | S021 | SDB | − | ++++ | − | − | +++ | ++++ | − | − | |
| Aspergillus | S022 | SDB | +++ | +++ | − | − | +++ | +++ | − | − | |
| Aspergillus | S023 | SDB | − | +++ | − | − | +++ | +++ | − | − | |
| Marine Host | Fungal Strain | Culture Media | Cell Lines | ||||||
|---|---|---|---|---|---|---|---|---|---|
| Genus | Strain | Breast MCF-7 | Hepatocellular HepG2 | Colorectal HCT-116 | |||||
| Broth | Mycelia | Broth | Mycelia | Broth | Mycelia | ||||
| S. carteri | Penicillium | S001 | CZYB | 75.44 | ˃100 | 79.26 | ˃100 | ˃100 | 92.60 |
| Aspergillus | S002 | CZYB | 73.28 | ˃100 | 61.96 | ˃100 | ˃100 | 48.00 | |
| Sediment | Penicillium | S003 | CZYB | 55.16 | ˃100 | 48.96 | ˃100 | ˃100 | 68.40 |
| Aspergillus | S004 | CZYB | 22.72 | 81.95 | 13.55 | ˃100 | 42.75 | 51.40 | |
| Aspergillus | S005 | CZYB | 70.29 | ˃100 | 60.22 | ˃100 | ˃100 | 70.66 | |
| Aspergillus | S006 | CZYB | 34.27 | 92.15 | 40.20 | ˃100 | 62.20 | ˃100 | |
| Aspergillus | S007 | CZYB | 60.50 | ˃100 | 65.63 | ˃100 | 87.00 | 80.00 | |
| Pleosporaceae | S008 | CZYB | 92.00 | ˃100 | ˃100 | ˃100 | ˃100 | ˃100 | |
| H. erectus | Aspergillus | S009 | MEB | ˃100 | ˃100 | ˃100 | ˃100 | ˃100 | ˃100 |
| Penicillium | S010 | MEB | 73.60 | ˃100 | ˃100 | ˃100 | ˃100 | ˃100 | |
| Penicillium | S011 | MEB | 57.67 | ˃100 | 83.20 | ˃100 | ˃100 | ˃100 | |
| Sediment | Aspergillus | S012 | MEB | ˃100 | 92.00 | 92.00 | ˃100 | ˃100 | 97.00 |
| Sediment | Aspergillus | S013 | MEB | 39.00 | 79.92 | 54.81 | 86.76 | 73.60 | 92.60 |
| H. erectus | Penicillium | S014 | SDB | 79.53 | ˃100 | 92.80 | ˃100 | ˃100 | ˃100 |
| S. carteri | Penicillium | S015 | SDB | 64.70 | ˃100 | 66.26 | ˃100 | 74.20 | 15.00 |
| Deep Sea | Aspergillus | S016 | SDB | 23.27 | 93.50 | 41.70 | 67.44 | 62.00 | 81.00 |
| Aspergillus | S017 | SDB | 42.26 | ˃100 | 54.40 | 99.08 | 53.16 | ˃100 | |
| Aspergillus | S018 | SDB | 60.48 | ˃100 | 97.70 | ˃100 | 90.00 | ˃100 | |
| Sediment | Aspergillus | S019 | SDB | 51.00 | ˃100 | 86.72 | ˃100 | 49.80 | ˃100 |
| Aspergillus | S020 | SDB | 44.00 | 81.95 | 57.00 | ˃100 | 47.83 | 67.00 | |
| Aspergillus | S021 | SDB | 89.93 | 68.15 | 63.29 | ˃100 | 74.60 | 89.66 | |
| Aspergillus | S022 | SDB | 65.12 | 87.00 | 91.80 | ˃100 | 81.60 | ˃100 | |
| Aspergillus | S023 | SDB | ˃100 | ˃100 | ˃100 | ˃100 | ˃100 | ˃100 | |
| Doxorubicin | 0.41 ± 0.1 | 0.85 ± 0.1 | 0.11 ± 0.04 | ||||||
| Isolate | Genus Identification | Sequence Length (bp) | Related Strain (BLAST) | Access No. | Similarity (%) |
|---|---|---|---|---|---|
| S001 | Penicillium sp. | 522 | Penicillium chrysogenum | KU556301 | 99% |
| S002 | Aspergillus sp. | 490 | Aspergillus cristatus | KT151565 | 98% |
| S003 | Penicillium sp. | 524 | P. chrysogenum | KX266831 | 98% |
| S004 | Aspergillus sp. | 531 | Aspergillus niger | KJ881377 | 95% |
| S005 | Aspergillus sp. | 530 | A. niger | KU904480 | 96% |
| S006 | Aspergillus sp. | 532 | Aspergillus flavus | HQ645940 | 99% |
| S007 | Aspergillus sp. | 530 | Aspergillus tubingensis | KX015988 | 97% |
| S008 | Pleosporaceae sp | 505 | Pleosporaceae sp. | KJ443264 | 97% |
| S009 | Aspergillus sp. | 629 | Aspergillus sp. | HQ023227 | 98% |
| S010 | Penicillium sp. | 534 | Penicillium polonicum | KF494148 | 99% |
| S011 | Penicillium sp. | 525 | P. polonicum | KP794074 | 98% |
| S012 | Aspergillus sp. | 527 | Aspergillus sp. | KX015994 | 97% |
| S013 | Aspergillus sp. | 502 | Aspergillus foveolatus | KU866615 | 99% |
| S014 | Penicillium sp. | 519 | P.chrysogenum | KX015998 | 98% |
| S015 | Penicillium sp. | 526 | P. chrysogenum | KU743900 | 98% |
| S016 | Aspergillus sp. | 523 | A. flavus | FJ216388 | 98% |
| S017 | Aspergillus sp. | 529 | A. flavus | KX015986 | 95% |
| S018 | Aspergillus sp. | 644 | A. niger | KT377250 | 99% |
| S019 | Aspergillus sp. | 438 | A. niger | LC195003 | 98% |
| S020 | Aspergillus sp. | 538 | Aspergillus terreus | KX694148 | 98% |
| S021 | Aspergillus sp. | 330 | Aspergillus sp. | KX000269 | 94% |
| S022 | Aspergillus sp. | 536 | Aspergillus fumigatus | KU743889 | 98% |
| S023 | Aspergillus sp. | 531 | Aspergillus sp. | KU842426 | 99% |
| Cell Type | Cell Line | Doxorubicin | Terrein |
|---|---|---|---|
| Colorectal | HCT-116 | 0.11 ± 0.04 | 12.13 |
| Hepatocellular | HepG2 | 0.85 ± 0.1 | 22.53 |
© 2019 by the authors. Licensee MDPI, Basel, Switzerland. This article is an open access article distributed under the terms and conditions of the Creative Commons Attribution (CC BY) license (http://creativecommons.org/licenses/by/4.0/).
Share and Cite
Asfour, H.Z.; Awan, Z.A.; Bagalagel, A.A.; Elfaky, M.A.; Abdelhameed, R.F.A.; Elhady, S.S. Large-Scale Production of Bioactive Terrein by Aspergillus terreus Strain S020 Isolated from the Saudi Coast of the Red Sea. Biomolecules 2019, 9, 480. https://doi.org/10.3390/biom9090480
Asfour HZ, Awan ZA, Bagalagel AA, Elfaky MA, Abdelhameed RFA, Elhady SS. Large-Scale Production of Bioactive Terrein by Aspergillus terreus Strain S020 Isolated from the Saudi Coast of the Red Sea. Biomolecules. 2019; 9(9):480. https://doi.org/10.3390/biom9090480
Chicago/Turabian StyleAsfour, Hani Z., Zuhier A. Awan, Alaa A. Bagalagel, Mahmoud A. Elfaky, Reda F. A. Abdelhameed, and Sameh S. Elhady. 2019. "Large-Scale Production of Bioactive Terrein by Aspergillus terreus Strain S020 Isolated from the Saudi Coast of the Red Sea" Biomolecules 9, no. 9: 480. https://doi.org/10.3390/biom9090480
APA StyleAsfour, H. Z., Awan, Z. A., Bagalagel, A. A., Elfaky, M. A., Abdelhameed, R. F. A., & Elhady, S. S. (2019). Large-Scale Production of Bioactive Terrein by Aspergillus terreus Strain S020 Isolated from the Saudi Coast of the Red Sea. Biomolecules, 9(9), 480. https://doi.org/10.3390/biom9090480

